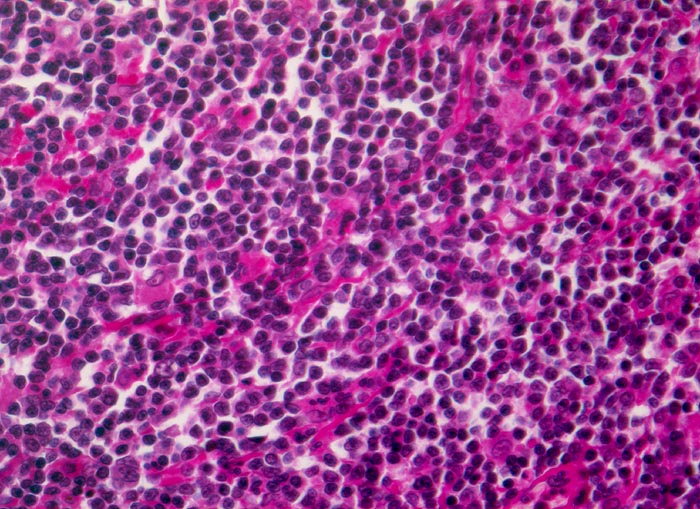

PathoPic – image database / PathoPic ID 3334 - extranodales Marginalzonenlymphom vom MALT-Typ
de
Diagnose
extranodales Marginalzonenlymphom vom MALT-Typ
Diagnose Gruppe
maligner Tumor
Topographie
Magen
Topographie Gruppe
Oesophagus, Magen
Beschreibung
Das monotone neoplastische Infiltrat besteht aus kleinen zentrozytoiden Zellen mit leicht entrundeten Kernen und wenig Zytoplasma.
Bilder Typ
Histologie
Alter
72
Geschlecht
männlich
Datum
Ersteintrag: 12.11.2001
Update: 04.02.2024